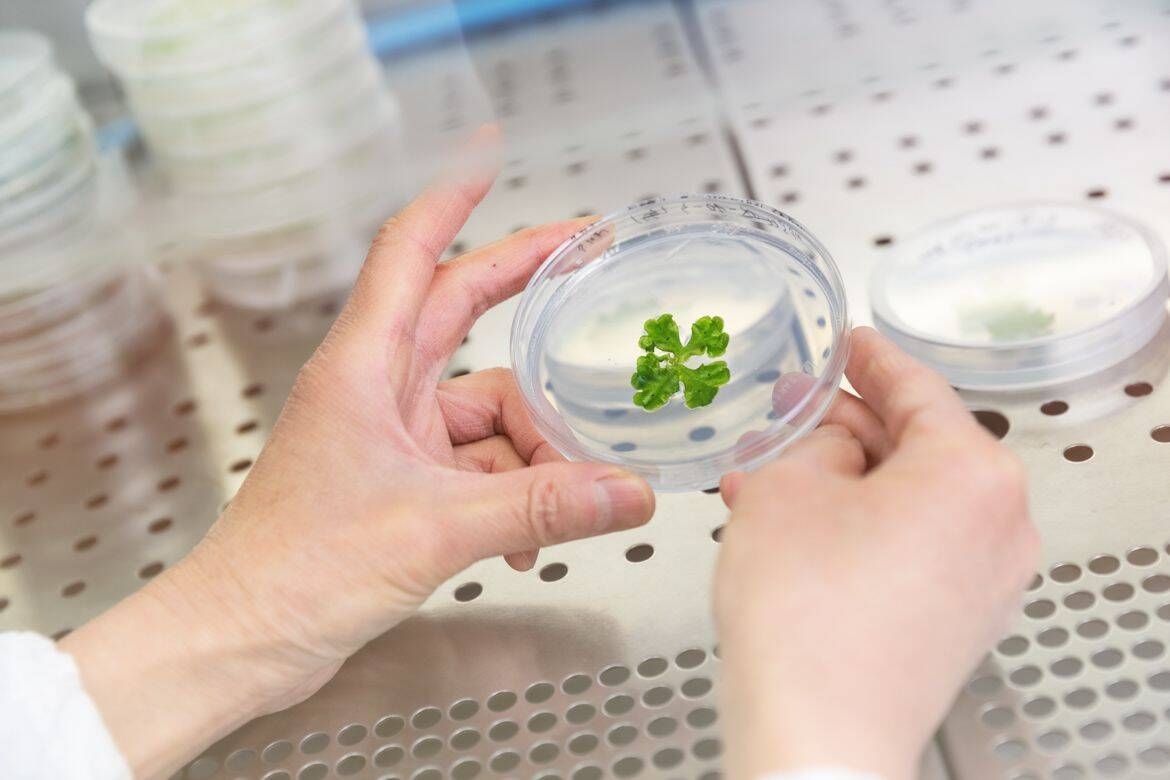
Immagine: Unità-Ecogenomica-2022-Foto-Marco-Parisi-5_Marchantia heavy metals (3)

BRYOMOLECULES esplora il potenziale delle briofite per i settori cosmetico e farmaceutico
COMUNICATO STAMPA
1 aprile 2026
Il progetto BRYOMOLECULES punta a scoprire composti naturali nascosti all’interno delle briofite, ampiamente diffuse in Europa. L’iniziativa sviluppa approcci sostenibili e all’avanguardia per valorizzare i composti bioattivi (BAC) presenti in queste piccole piante, con applicazioni nei settori cosmetico e farmaceutico.
Attraverso l’avanzamento delle conoscenze e delle applicazioni innovative sulle briofite, il progetto mira a promuovere la crescita economica creando innovazioni bio-based commercializzabili e brevettabili, contribuendo all’economia circolare e sostenendo lo sviluppo di industrie sostenibili in Europa.
Dopo 18 mesi di ricerca e collaborazione tra partner accademici e industriali, il progetto BRYOMOLECULES sta compiendo progressi significativi nello studio delle briofite — muschi ed epatiche che crescono silenziosamente in foreste, zone umide e ambienti rocciosi.
Raccolta e coltivazione di epatiche e muschi
I partner della Lund University hanno sviluppato colture asettiche di 50 accessioni di muschi e 50 di epatiche, che costituiranno la base per numerosi studi successivi del progetto. La collezione rappresenta un’ampia diversità di specie, con materiale raccolto principalmente in Svezia e ulteriori campioni provenienti da Islanda, Isole Faroe e Italia.
Per garantire condizioni di laboratorio controllate, il materiale vegetale viene sottoposto a un accurato processo di sterilizzazione prima della coltivazione in terreni specifici. Queste colture sterili consentono agli scienziati di studiare le piante senza interferenze da parte di altri microrganismi e sono mantenute in condizioni controllate di luce e temperatura, offrendo una risorsa stabile per analisi biologiche e chimiche future.
Explore the collection of liverworts in our project deliverables:
•D1.1 Lista delle accessioni di muschi
•D1.2 Lista delle nuove epatiche collezionate
•D1.3 Inclusione di oltre 40 accessioni axeniche di epatiche nella collezione di colture di briofite
Analisi metabolomica delle briofite
Un’altra componente chiave del progetto è guidata dalla Medical University of Lublin, dove i ricercatori stanno analizzando la composizione chimica degli estratti di muschi ed epatiche.
Ad oggi sono state studiate 57 accessioni di muschi e 86 di epatiche, tra campioni coltivati in laboratorio e raccolti in natura. Tra questi, sono inclusi diversi esemplari di Marchantia polymorpha, una delle epatiche più conosciute, rappresentata nelle sue diverse sottospecie.
Il materiale vegetale viene processato per estrarre i composti biochimici, successivamente analizzati tramite tecniche avanzate di spettrometria di massa e cromatografia. Questi metodi permettono di identificare e catalogare il profilo metabolomico delle piante, ovvero l’insieme delle molecole prodotte dalle briofite.
I risultati stanno contribuendo alla creazione di una libreria crescente di composti derivati dalle briofite, che potranno essere studiati per future applicazioni in cosmetica, farmaceutica e altri ambiti.
Maggiori dettagli sono disponibili nelle deliverables di progetto:
•D2.1 Report on phytochemical profile of 50 moss accessions
•D2.2 Report on phytochemical profile of 80 collected liverwort accessions
Mappatura genetica delle briofite
Accanto agli studi fitochimici, il progetto esplora anche il profilo genetico delle briofite per comprendere il ruolo dell’attività genica nella produzione di molecole bioattive.
I ricercatori della Fondazione Edmund Mach hanno prodotto dati relativi all’assemblaggio di 102 trascrittomi di briofite generati tramite piattaforma Illumina. Le sequenze, ricostruite a partire da dati RNA-Seq, saranno rese disponibili attraverso il GenBank Short Read Archive, a supporto della ricerca attuale e futura.
Maggiori informazioni sono reperibili nelle deliverables di progetto:
•D3.1 Raw sequences for 90 bryophyte transcriptomes
•D3.2 Assemblies of 90 bryophyte transcriptomes
Valorizzazione dei risultati
Parallelamente ai progressi scientifici, Fondazione Hub Innovazione Trentino ha guidato lo sviluppo di un piano di valorizzazione dei risultati, comprensivo di un’analisi di mercato nel settore delle fragranze naturali e della cosmetica.
È stato inoltre definito un piano di gestione della proprietà intellettuale (IPR) per monitorare i risultati attesi, tra cui:
- protocolli ottimizzati per la coltivazione delle epatiche
- metodi sostenibili per la produzione ed estrazione dei composti bioattivi
- biosintesi dei BAC in sistemi ingegnerizzati
- nuovi ingredienti bioattivi per cosmetica e farmaceutica
- database di composti e geni biosintetici
- pipeline per attività di bioprospecting
Verso le prossime fasi
A metà del suo percorso, BRYOMOLECULES ha già costruito una solida base scientifica: collezioni di briofite coltivate, ampi dataset chimici e genetici e una prima comprensione dei meccanismi di produzione dei composti.
Questa base sarà fondamentale per le prossime fasi, che includeranno la valutazione della bioattività, il miglioramento delle vie biosintetiche e l’identificazione di molecole promettenti.
Nei prossimi mesi, i partner continueranno a lavorare per tradurre questi risultati in applicazioni sostenibili per i settori cosmetico e farmaceutico, coinvolgendo progressivamente gli attori della filiera.
Il progetto invita tutti i soggetti interessati a entrare in contatto per approfondire i risultati o seguire gli sviluppi della ricerca.
Partner
•Fondazione Edmund Mach - Project coordinator
•ESF -European Science Foundation
•Fondazione HUB Innovazione Trentino
•Plant Advanced Technologies SA
•Laboratoire Biotechnologies Végétales appliquées aux plantes aromatiques et médicinales (LBVpam)
•Uniwersytet Medyczny w Lublinie
Esplora i risultati del progetto